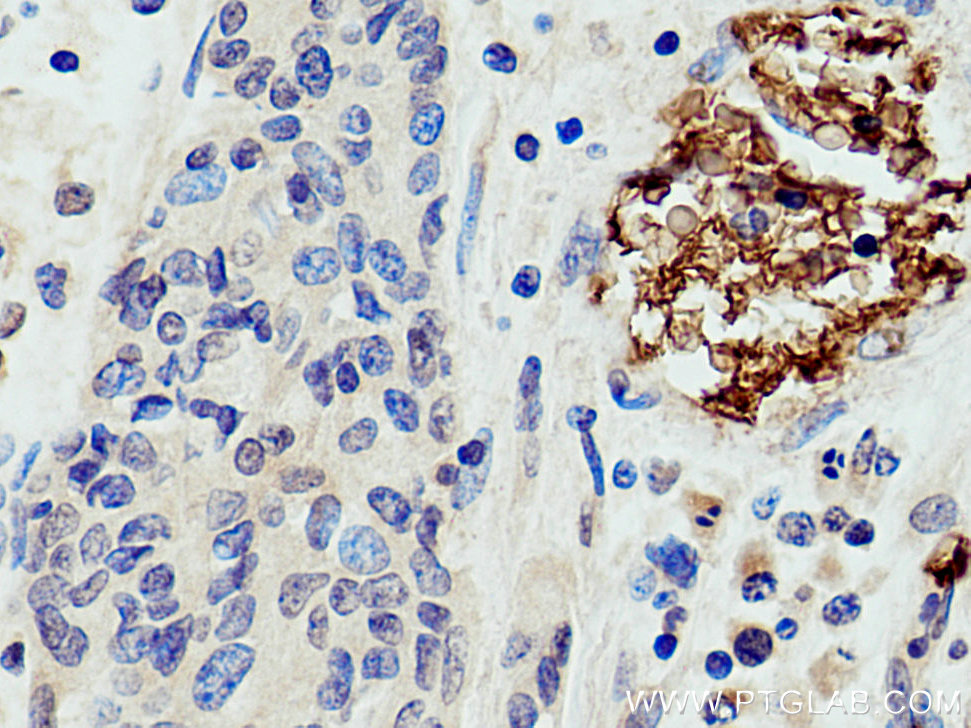

验证数据展示
经过测试的应用
| Positive WB detected in | HepG2 cells |
| Positive IP detected in | mouse liver tissue |
| Positive IHC detected in | human spleen tissue, human stomach cancer tissue, human kidney tissue Note: suggested antigen retrieval with TE buffer pH 9.0; (*) Alternatively, antigen retrieval may be performed with citrate buffer pH 6.0 |
| Positive IF-P detected in | human placenta tissue |
推荐稀释比
| 应用 | 推荐稀释比 |
|---|---|
| Western Blot (WB) | WB : 1:200-1:1000 |
| Immunoprecipitation (IP) | IP : 0.5-4.0 ug for 1.0-3.0 mg of total protein lysate |
| Immunohistochemistry (IHC) | IHC : 1:20-1:200 |
| Immunofluorescence (IF)-P | IF-P : 1:50-1:500 |
| It is recommended that this reagent should be titrated in each testing system to obtain optimal results. | |
| Sample-dependent, Check data in validation data gallery. | |
产品信息
18566-1-AP targets Band 3/AE 1 in WB, IHC, IF-P, IP, ELISA applications and shows reactivity with human, mouse, rat samples.
| 经测试应用 | WB, IHC, IF-P, IP, ELISA Application Description |
| 文献引用应用 | WB, IHC, IF |
| 经测试反应性 | human, mouse, rat |
| 文献引用反应性 | human, mouse, rat, plasmodium falciparum |
| 免疫原 |
CatNo: Ag13076 Product name: Recombinant human SLC4A1 protein Source: e coli.-derived, PKG Tag: GST Domain: 1-353 aa of BC101570 Sequence: MEELQDDYEDMMEENLEQEEYEDPDIPESQMEEPAAHDTEATATDYHTTSHPGTHKVYVELQELVMDEKNQELRWMEAARWVQLEENLGENGAWGRPHLSHLTFWSLLELRRVFTKGTVLLDLQETSLAGVANQLLDRFIFEDQIRPQDREELLRALLLKHSHAGELEALGGVKPAVLTRSGDPSQPLLPQHSSLETQLFCEQGDGGTEGHSPSGILEKIPPDSEATLVLVGRADFLEQPVLGFVRLQEAAELEAVELPVPIRFLFVLLGPEAPHIDYTQLGRAAATLMSERVFRIDAYMAQSRGELLHSLEGFLDCSLVLPPTDAPSEQALLSLVPVQRELLRRRYQSSPAK 种属同源性预测 |
| 宿主/亚型 | Rabbit / IgG |
| 抗体类别 | Polyclonal |
| 产品类型 | Antibody |
| 全称 | solute carrier family 4, anion exchanger, member 1 (erythrocyte membrane protein band 3, Diego blood group) |
| 别名 | band 3, band 3/ AE1, SLC4A1, Band 3 anion transport protein, Anion exchanger 1 |
| 计算分子量 | 911 aa, 102 kDa |
| 观测分子量 | 95 kDa, 50 kDa |
| GenBank蛋白编号 | BC101570 |
| 基因名称 | band 3 |
| Gene ID (NCBI) | 6521 |
| RRID | AB_10642570 |
| 偶联类型 | Unconjugated |
| 形式 | Liquid |
| 纯化方式 | Antigen affinity purification |
| UNIPROT ID | P02730 |
| 储存缓冲液 | PBS with 0.02% sodium azide and 50% glycerol, pH 7.3. |
| 储存条件 | Store at -20°C. Stable for one year after shipment. Aliquoting is unnecessary for -20oC storage. |
背景介绍
Anion exchanger 1 (AE1), also known as band 3, is a 95-100 kDa transmembrane glycoprotein which is abundantly expressed in erythrocyte plasma membrane and mediates the electroneutral exchange of Cl- and HCO3-. It contains a 52-55 kDa C-terminal membrane crossing domain and a 43 kDa N-terminal cytoplasmic domain. Degradation of band 3 protein occurred during erythrocyte aging. The oxidative stress can also activate the proteolysis of band 3 through caspases. This antibody is expected to recognize the intact band 3 (95-100 kDa) and various degradation products (38-60 kDa). (PMID: 22890269, 29240292, 28130418)
发表文章
| Species | Application | Title |
|---|---|---|
Blood Ferroportin deficiency in erythroid cells causes serum iron deficiency and promotes hemolysis due to oxidative stress. | ||
Sci Adv Red blood cell-derived nanoerythrosome for antigen delivery with enhanced cancer immunotherapy. | ||
J Proteome Res Proximity Proteomics Has Potential for Extracellular Vesicle Identification. | ||
Stem Cells Int Pyridoxal-5'-Phosphate Promotes Immunomodulatory Function of Adipose-Derived Mesenchymal Stem Cells through Indoleamine 2,3-Dioxygenase-1 and TLR4/NF-κB Pathway. | ||
PLoS One Mechanisms that determine the internal environment of the developing brain: a transcriptomic, functional and ultrastructural approach. | ||
Front Neurosci Influx mechanisms in the embryonic and adult rat choroid plexus: a transcriptome study. |